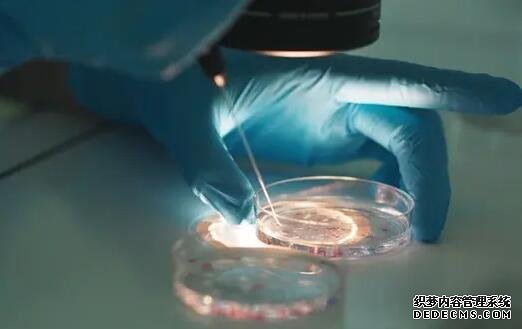
上海代怀先询精因宝贝 上海最好的试管医院 ‘四维彩超mi是男孩还是女孩’

)15:43( 自己醒了,就赖叽。供精试管婴儿不同于供精人授,一般情况下,男性不孕比较严重的情况可以申请做供精试管,还有女性多次人工授精不成功的情况也可以采用此技术,只是
上海代怀先询精因宝贝以治疗不孕不育症和妇科疾病为主的综合医院,称得上是物美价廉,试管助孕,一对一服务圆您生儿育女梦!
上海瑞金医院做试管婴儿成功率
上海瑞金医院生殖医学中心的试管婴儿成功率常年保持在50%-60%左右,该中心的种植率和妊娠率保持在国内先进水平。另外,25-34岁女性的试管婴儿手术成功率最高。35岁以后,成功率会明显下降。40岁以后,成功率会在20%左右,且活产率明显下降,对优生也会有很大的影响。45岁以上就不能用自己的卵子做试管婴儿治疗了,因为成功率极低,而且胚胎及容易出现染色体异常情况。在试管婴儿的治疗中,高龄女性的流产率会大大增加,早产和死胎也高于年轻女性。
在上海一妇婴申请供精试管要满足什么条件?
上海一妇婴说的是上海市第一妇婴保健院,该医院已经具备开展生殖辅助技术的资质。目前可以做夫精、供精人工授精、一代、二代、三代试管,可以进行比较全面的试管。在该医院做供精试管不是任何人都可以做的,需要满足适应症,比如男方没有精子,患还在女方试管多次失败等情况,当然必须提供身份证、结婚证、以及相关的检查报告。
上海一妇婴供精试管条件:随着生活水平的提高,科学技术的发展,男性不孕人数也在增加,为了解决男性的生育问题,选择上海一妇婴做供精试管是一个不错的决定,只是需要满足一定的条件,具体如下。
1.以前在我国做试管婴儿需要三证,身份证、准生证、结婚证,现在准生证被取缔,需要准备身份证、结婚证;
2.但当然还需要满足一定的适应症,比如男方有严重的少精症、弱精症、畸形精子率高的情况;
3.又或者女方有输卵管堵塞、多囊卵巢综合症等疾病导致身体无法做人工授精的,才可以选择申请精子库的精子做试管;
4.还有男方有遗传性疾病,精子中携带了遗传疾病的基因的情况。
由于我国试管婴儿要求比较严格,所以上海市第一妇婴保健院以及其他的医院申请供精试管都是需要满足一定条件的。供精试管婴儿不同于供精人授,一般情况下,男性不孕比较严重的情况可以申请做供精试管,还有女性多次人工授精不成功的情况也可以采用此技术,只是不是任何人任何医院都可以做的,需要是合法夫妻有身份证、结婚证等证件。上海最好的试管医院

1、上海最好的试管医院非九院莫属,这家医院的试管成功率在上海是最好的,主要是因为这家医院的专家团队庞大,他们有丰富的试管经验,另外,医院的设备也是一流的。
2、上海交通大学医学院附属第九人民医院简称上海九院,医院的辅助生殖科成立于2003年,是卫生部批准的开展辅助生殖技术的医疗机构,专业治疗各种不孕不育症。
3、医院可以开展夫精人工授精(AIH)、体外受精-胚胎移植(IVF-ET)和卵细胞浆内单精子注射(ICSI)、胚胎玻璃化冷冻、稀少精子冷冻等辅助生殖技术。
4、现任科主任以及学科带头人匡延平教授,是辅助生殖领域的专家,同时兼任上海医学会生殖医学分会副主任委员,中华医学会中西医结合辅助生殖医学分会委员,目前中心有主任医师1人、副主任医师7人,有研究生学历的占83.3%,博士生导师1人,硕士生导师4人。
5、中心具备全层流的取卵手术室、胚胎移植室、胚胎培养室、显微操作室、精液制备室胚胎冷冻及液氮储存室、宫腔镜手术室,配备了多台先进的超声诊断仪和胚胎实验操作所需要的全套设备。
6、中心还开展了常规的附睾、睾丸穿刺、宫腔镜手术、卵巢囊肿穿刺、子宫内膜活检、盆腔输卵管显影、输卵管栓堵技术等等。
7、医院2016年门诊量已达33.5万人次,新鲜取卵周期数16000,胚胎移植周期数12000,规模居国际前五,该中心全年无休、节假日照常上班、不设专家门诊、不限号,可以真正的做到以病人为中心。
很多不孕不孕的家庭都因为上海九院的试管技术而慕名前来,所以想要在这家医院做试管的人要提前预约,而且可能预约的时间也要久一点,大家看好了医院就要提前预约好。网友经历
7:51( 吃锌!)
( 玩了一会儿,还好没赖叽。)
8:28( 哄睡觉!)
9:30( 醒了!)
( 去医院一趟。一言难尽。)
11:46( 回家喂孩子吃奶!)
( 不干了,委屈委屈的。给他大姑整一身汗。说咋滴也不行了。)
(吃完奶睡着了!)
13:05( 醒了!)
( 让他自己在床上玩一会儿,我太困了就迷糊一会儿,也不敢睡实,还得时不时睁眼睛看看,怕他掉地上。不过好在他挺老实这次,没有乱翻。就是在那乱乱的自己说话。)
13:41( 吃AD!)
14:12(吃益生菌!)
( 本来打算带他出去玩一圈,结果打雷要下雨,几滴小雨点,出不去了。在阳光房里玩一会儿赖叽了。)
15:06( 哄睡觉!)
15:43( 自己醒了,就赖叽!)
15:57( 吃奶!)
( 边吃奶边睡觉,我俩一起睡。)
18:00左右( 醒了!)
18:20(拉粑粑一次!)
18:45左右( 出来溜达玩,有点冷!)
19:20( 回家吃米粉!)
温馨提示
血友病患者内脏出血情况非常危险,如果不及时补充凝血因子,患者会出现消化道出血、腹腔出血、肾出血等内脏出血的情况,一旦患者出现了中枢系统颅内出血,会直接威胁到患者的生命。当身体有出血症状的时候,容易形成局部血肿,甚至会对神经造成压迫,如果血肿压迫在颈部,很可能会导致窒息和血压下降,导致死亡。如果是轻症的患者,也需要警惕出血情况。
上一篇:
秋季光照不足,宝宝需防佝偻病










